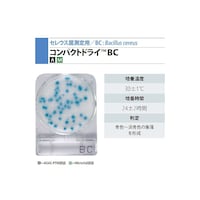
�R���p�N�g�h���C�i�s�l�j
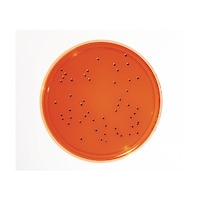
�l���������@��������������|�n�@�w�k�c�A�K�[�@�i�R�O���k�~�Q�O�����j�@�P�D�S�U�O�V�R�D�O�O�Q�O

コンパクトドライ(TM)
+もっと見る
キッコーマンバイオ EasyPlate
+もっと見る
栄研化学 ぺたんチェック(R)10 PTシリーズ
ぺたんと押して微生物チェックします。特定の汚染菌の有無を選択的に確認できます。一般細菌検出用培地は最短8時間で判定が可能です(発色液を使用)。
ぺたんと押して微生物チェックします。特定の汚染菌の有無を選択的に確認できます。一般細菌検出用培地は最短8時間で判定が可能です(発色液を使用)。+もっと見る
アズワン サニスペック生培地 20枚入
培地調製の手間が省け、すぐお使いいただけます。細菌検査の初心者から熟練者の方まで幅広くお使いいただけます。今まで平板培地の作成に必要だった培地の調製・器具の洗浄・粉末培地・試薬等の在庫管理を行う必要が
培地調製の手間が省け、すぐお使いいただけます。細菌検査の初心者から熟練者の方まで幅広くお使いいただけます。今まで平板培地の作成に必要だった培地の調製・器具の洗浄・粉末培地・試薬等の在庫管理を行う必要が+もっと見る
サン化学 サンコリ簡易菌検出紙 (カビ|酵母用)1箱(100枚入) 00007 培地 簡易培地 1箱(100枚)
カビの場合は、カビ特有の色調。酵母は濃い灰色に出ます。
カビの場合は、カビ特有の色調。酵母は濃い灰色に出ます。+もっと見る
ADVANTEC 培地注入筒(アンプル培地注入専用針付)1 42011810 培地関連用品 1箱
容量1mLの滅菌済みディスポーザブルプラスチック製シリンジです。37mmモニターによる培養の際、モニターの裏側から吸収パッドへ培地を注入するときに用います。
容量1mLの滅菌済みディスポーザブルプラスチック製シリンジです。37mmモニターによる培養の際、モニターの裏側から吸収パッドへ培地を注入するときに用います。+もっと見る
日本ベクトン・ディッキンソン BD BBL(TM) コロンビアCNA5%ヒツジ血液寒天培地/マッコンキー2寒天培地 20枚 251600 培地 その他 1個(20枚)
本培地は、1枚で2種類の培地が併用できる様に組合わされた便利で効率の良い培地です。
本培地は、1枚で2種類の培地が併用できる様に組合わされた便利で効率の良い培地です。+もっと見る
サン化学 滅菌サンパック (100枚入) 12 培地関連用品 1袋
滅菌済でディスポタイプのビニール袋です。チャック袋長さ16cm(チャック下14cm)幅5cmビーカーの代わりに使用します滅菌計量棒とサンコリ検体作製水を使うことで希釈倍率を行えます検食の小分け袋として
滅菌済でディスポタイプのビニール袋です。チャック袋長さ16cm(チャック下14cm)幅5cmビーカーの代わりに使用します滅菌計量棒とサンコリ検体作製水を使うことで希釈倍率を行えます検食の小分け袋として+もっと見る
日本ベクトン・ディッキンソン BD Difco(TM) ラフィノース 217410 培地 その他 1本
D(+)ラフィノース五水和物、単糖類です。
D(+)ラフィノース五水和物、単糖類です。+もっと見る
Merck 粉末培地 (レディーカルトコリフォーム50) 1.01295.0001
粉末培地 (レディーカルトコリフォーム50) は信頼と実績に優れた商品です。
粉末培地 (レディーカルトコリフォーム50) は信頼と実績に優れた商品です。+もっと見る
Merck 粉末培地 (レディーカルトコリフォーム100) 1.01298.0001
粉末培地 (レディーカルトコリフォーム100) は信頼と実績に優れた商品です。
粉末培地 (レディーカルトコリフォーム100) は信頼と実績に優れた商品です。+もっと見る
Merck 粉末培地 (ブレインハートイン ヒュジョンブイヨン) 500g 1.10493.0500
粉末培地 (ブレインハートイン ヒュジョンブイヨン) 500g は信頼と実績に優れた商品です。
粉末培地 (ブレインハートイン ヒュジョンブイヨン) 500g は信頼と実績に優れた商品です。+もっと見る
Merck 粉末培地 (バルカム・リステリア選択剤) 1.12122.0010
粉末培地 (バルカム・リステリア選択剤) は信頼と実績に優れた商品です。
粉末培地 (バルカム・リステリア選択剤) は信頼と実績に優れた商品です。+もっと見る
Merck 粉末培地 (ボルトンブイヨン選択剤) 1.00079.0010
粉末培地 (ボルトンブイヨン選択剤) は信頼と実績に優れた商品です。
粉末培地 (ボルトンブイヨン選択剤) は信頼と実績に優れた商品です。+もっと見る
日本ベクトン・ディッキンソン BD Difco(TM) ラパポート VAS(MSRV) 218681 培地 その他 1個
ラパポートバシリアジス(MSRV)培地の半流動化改良品です。
ラパポートバシリアジス(MSRV)培地の半流動化改良品です。+もっと見る
Merck 粉末培地 クロストリジア ブイヨン クロストリジア(DRCM) 1.11699.0500
粉末培地 クロストリジア ブイヨン クロストリジア(DRCM) は信頼と実績に優れた商品です。
粉末培地 クロストリジア ブイヨン クロストリジア(DRCM) は信頼と実績に優れた商品です。+もっと見る
日本ベクトン・ディッキンソン BD Difco(TM) M FCブロス基礎培地 500g 288330 培地 その他 1個
ロゾリック酸(No.232281)と共に使用します。
ロゾリック酸(No.232281)と共に使用します。+もっと見る
日本ベクトン・ディッキンソン BD Difco(TM) ポリミキシンB 1個(6本入) 232681 培地 その他 1個(6本)
抗生物質:ポリミキシンBです。
抗生物質:ポリミキシンBです。+もっと見る